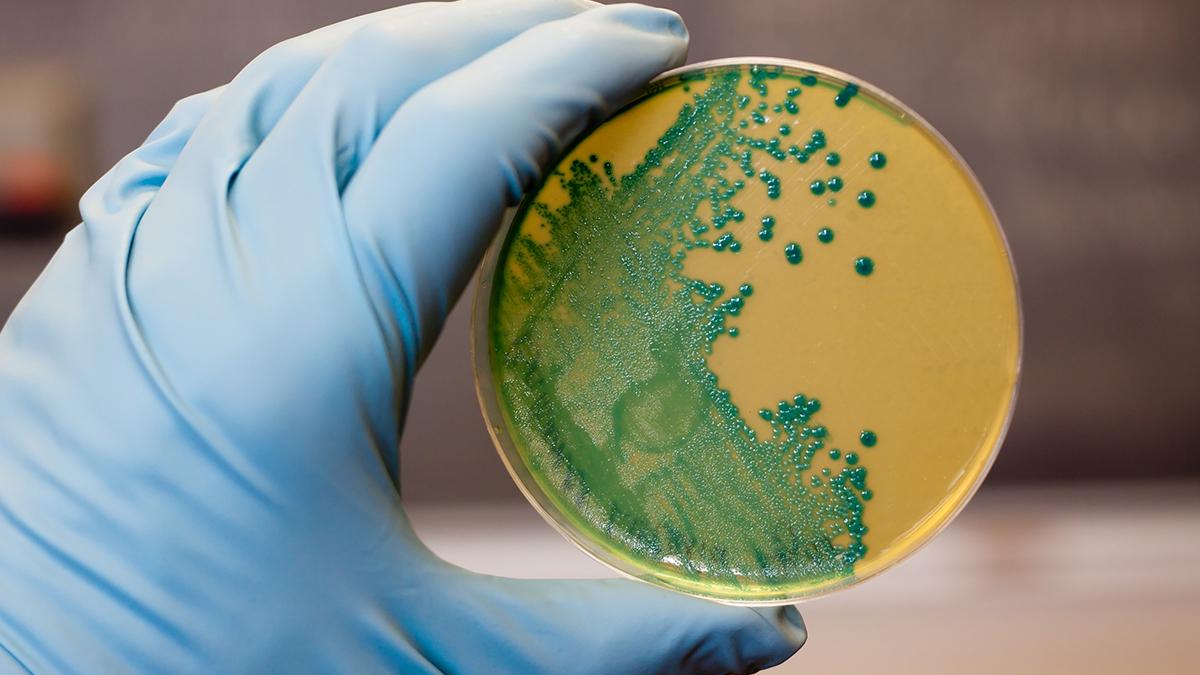
Antimikrobiyal direnç kanalizasyonda gizleniyor

Antimikrobiyal direnç kanalizasyonda gizleniyor
Uluslararası araştırmacılar, dünyanın 111 ülkesindeki atık sularında ilaçlara dirençli bakterilerin geleceğini belirleyecek gizli genetik kodlar buldu. Bilim insanları, henüz aktif olmayan ancak belirli koşullarda tehlikeli hale gelebilecek bu direnç genlerinin, bilinen dirençten daha yaygın olduğunu ortaya koydular.
Hastalık yapıcı mikroplar ve zararlı bakteriler, yaşam kurtaran antibiyotik ilaçlarımıza karşı giderek daha etkili savunma mekanizmaları geliştirerek antimikrobiyal direnç olarak bilinen ciddi bir sorunu ortaya çıkarmaktadırlar. Bu tehlikeli eğilim, insanların istemeden bu patojenleri sınırlı bağışıklık sistemlerine aşırı maruz bırakması nedeniyle hızlanmaktadır. Günümüzde ilaç dirençli bakteriler yılda bir milyondan fazla insanın ölümüne neden olmakta, araştırmacılar ise bu "süper mikropların" gelecekteki tehdidini anlamak için dünyanın atık su sistemlerini incelemektedir.
Küresel araştırmanın kapsamı ve bulguları
Uluslararası bir araştırmacı ekibi tarafından gerçekleştirilen kapsamlı bir çalışma, antimikrobiyal direncin fark ettiğimizden çok daha yaygın olduğunu ortaya koymaktadır. Araştırmacılar, dünyanın dört bir yanından 111 ülkede yer alan 351 şehirden toplam 1.240 kanalizasyon örneğini inceleyerek antimikrobiyal direnç genlerini (ARG'ler) aramışlardır. Bu kapsamlı araştırma, yaşam kurtaran ilaçlarımıza karşı mikroplara koruma sağlayan bu direnç genlerinin nerede ve ne kadar yaygın olduğunu belirlemek amacıyla gerçekleştirilmiştir. Bilim insanları, sadece bilinen direnç genlerini değil, aynı zamanda gizli genetik varyasyonları da tespit etmek için fonksiyonel metagenomik adı verilen ileri bir analiz yöntemi kullanmışlardır.
Gizli direnç genlerinin tehlikesi ve potansiyeli
Araştırmanın en önemli bulgusu, gizli antimikrobiyal direnç genlerinin neredeyse her yerde bol miktarda bulunduğu ve bunların küresel çapta gizli bir kütüphane oluşturduğu yönündedir. Bu gizli genler, bir organizmanın DNA'sında mevcut olmakla birlikte şu anda aktif olarak ifade edilmemektedir; ancak belirli çevresel koşullar altında uyandırılabilir ve aktif hale gelebilirler. Bu durum, gizli antimikrobiyal direnç genlerinin ilaç dirençli "süper mikropların" zayıf anlaşılan evriminde kritik roller oynayabileceği anlamına gelmektedir. Dikkate değer bir bulgu, bu gizli direnç genlerinin, zaten aktif veya kazanılmış genler tarafından sağlanan bilinen dirençten bile daha yaygın olduğu yönündedir.
Danimarka Teknik Üniversitesi'nde biyoinformatikçi olarak çalışan araştırmanın ilk yazarı Hannah-Marie Martiny, "Araştırma, beklediğimizden çok daha fazla dünya çapında yaygın olan gizli bir antimikrobiyal direnç rezervuarına sahip olduğumuzu gösteriyor" ifadesini kullanmıştır. Araştırmacılar, bu gizli direnç genlerinin bu kadar yaygın olmasının nedeninin, seçilim ve rekabetin bu genler arasında dağılımdan daha büyük bir rol oynaması olduğunu belirtmektedir.
Atık su gözetiminin önemi ve geleceği
Bu önemli keşiften çıkan en dikkate değer sonuç, atık su gözetiminin daha proaktif ve kapsamlı bir şekilde yapılması gerekliliğidir. DTU Ulusal Gıda Enstitüsü'nde doçent olan araştırmanın ortak ilk yazarı Patrick Munk, gelecekteki antimikrobiyal direnci frenlemek için atık sularda yapılan gözetimin sadece mevcut direnç genlerini değil, aynı zamanda gizli direnç genlerini de kapsaması gerektiğini vurgulamaktadır. Bu yaklaşım, bugünün sorunlarını çözerken aynı zamanda yarının potansiyel tehditlerine karşı da hazırlıklı olmayı sağlayacaktır.
Araştırmacılar, kanalizasyon gözetimini genişletirse gizli antimikrobiyal direnç genlerinden değerli bilgiler öğrenebileceklerini belirtmektedir. Bu bilgiler, araştırmacıların antimikrobiyal direncin kökenlerini aydınlatmasına, ilgili genlerin ekolojisini haritalandırmasına ve bu genler arasındaki karmaşık ilişkileri anlamasına yardımcı olabilir. Martiny, hem edinilmiş hem de gizli antimikrobiyal direnç genlerini izleyerek, bunların nasıl geliştiğine, konakçıları nasıl değiştirdiğine ve çevremizde nasıl yayıldığına dair geniş bir genel bakış elde edilebileceğini ifade etmektedir.
Atık su izlemesinin pratik ve etik avantajları
Atık su, antimikrobiyal direnci izlemek için son derece pratik ve etik bir yol sunmaktadır; çünkü insanlardan, hayvanlardan ve yakın çevreden gelen atıkları bir araya getirmektedir. Bu bütünsel yaklaşım, antimikrobiyal direncin tüm kaynaklarını ve yayılım yollarını anlamak için ideal bir fırsat sağlamaktadır. Araştırmacılar, bu tür bir gözetim sisteminin, gelecekte hangi mikropların hangi antimikrobiyal tedavilere karşı savunmasız olabileceğini tahmin etmemize yardımcı olabileceğini belirtmektedir.
Munk, yeni antibiyotikler geliştirildiğinde – bu uzun yıllar alan bir süreç – bakterilerin zaten bu yeni ilaçları yok edebilecek yeni "makaslar" icat etmiş olabileceğini uyarı olarak sunmaktadır. Bu nedenle, her iki gen türünü de zaman içinde inceleyebilirsek, gizli genlerden hangilerinin sorunlu direnç genleri haline geldiğini, nasıl ortaya çıktıklarını ve coğrafya ile bakteriler arasında nasıl yayıldıklarını öğrenebilir ve böylece antimikrobiyal direnç yükünü azaltabiliriz.
Gelecek perspektifi ve sonuç
Araştırmacılar, bu genlerin çoğunun şu anda halk sağlığını doğrudan tehlikeye atmayabileceğini, ancak bunlardan bazılarının muhtemelen gelecekte ciddi sorunlar oluşturacağını belirtmektedir. Martiny, genel olarak çoğu gizli antimikrobiyal direnç geni hakkında aşırı endişelenmemesi gerektiğini, ancak bunlardan bazılarının sonunda sorunlara neden olacağına inandığını ve hangilerinin olduğunu bilmenin önemli olduğunu vurgulamaktadır. Bu bilgi, gelecekteki antimikrobiyal dirençle mücadelenin daha etkili ve hedefli bir şekilde yapılmasını mümkün kılacaktır.
Sonuç olarak, bu araştırma, antimikrobiyal direncin sadece mevcut bir tehdit değil, aynı zamanda gelecek nesiller için de ciddi bir risk oluşturduğunu göstermektedir. Atık su gözetiminin genişletilmesi ve gizli direnç genlerinin sistematik olarak izlenmesi, bu küresel sağlık sorununa karşı daha etkili bir savunma stratejisi geliştirmemize yardımcı olacaktır. Bilim insanları, proaktif bir yaklaşım benimsenirse, antimikrobiyal direncin yükünü önemli ölçüde azaltmanın mümkün olduğuna inanmaktadırlar.
- Popüler Haberler -

Bilim dünyası erik ile bağırsak sağlığına yeni bir kapı araladı

Sağlıklı içeceklerde gizli tehlike! Bir porsiyonu 700 kaloriye ulaşabiliyor

Kadınlarda gizli kalp riski! Bu 5 alışkanlık tehlike saçıyor

Metabolizma hızınızı etkileyen gerçekler neler? İşte yanlış bilinenler ve bilimsel veriler

Ozempic ve Wegovy ile küresel obezite tedavisinde yeni dönem

10 bin 800 yaşlı üzerinde yapılan araştırmada müzikle demans riski yüzde 39 azaltıldı













